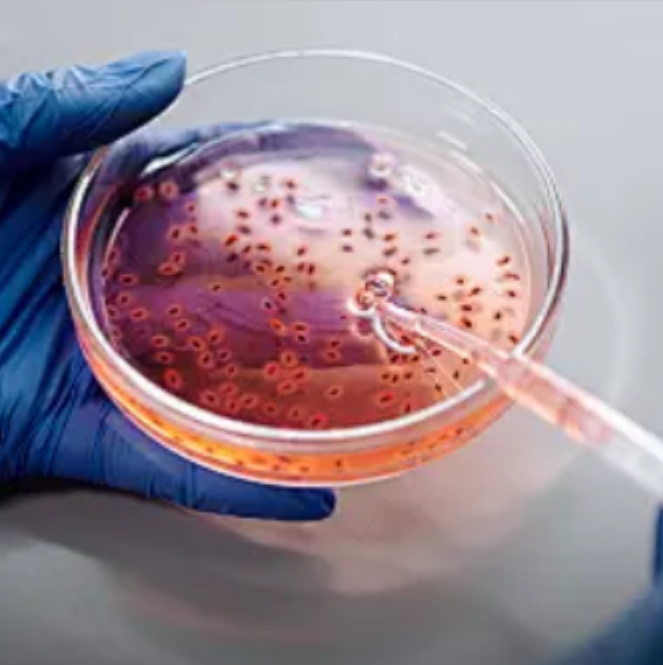

正熙生物
国内流式荧光检测技术领域的破题者
了解更多
About
Products
Academic
News
Join Us
About
Member
Guide
Hot Products
Hot Products
Customize
Product Category
Hot Products

Recommended products
Application area
Company Overview
正熙生物是一家以高通量细胞培养技术、抗体制备技术、抗体纯化技术、抗体偶联技术四大技术平台为核心的创新型高科技公司,主营业务为高质量低成本的单抗生产,以自有抗体为基础的科研型,诊断型流式荧光抗体高端试剂生产开发,和第三方医学特检服务。正熙生物基于底层抗体核心能力+标记技术,纵向逐步延伸流式细胞,流式荧光检测临床应用,横向同时构建多组学抗体试剂矩阵,渗透多组学新兴应用上游。 公司入选浙江省钱江人才计划和南太湖精英计划,入库国家科技型中小型企业,省级高新技术企业研发中心, 浙江省专精特新中小企业,国家高新技术企业。

上海(营销中心):上海市长宁区遵义路150号虹桥南丰城C座902室
客服电话:4008019029
联系邮箱:sales@zxbiopharm.com
杭州(第三方医学检验中心)::浙江省杭州市余杭区良渚街道仅家渡路112号6号楼1层
客服电话:4008019029
联系邮箱:info@zxbiopharm.com
浙江湖州(生产研发中心)::浙江省湖州市德清县阜溪街道长虹东街926号1幢3楼,3幢3楼、4楼(莫干山国家高新区)
客服电话:4008019029
联系邮箱:info@zxbiopharm.com
